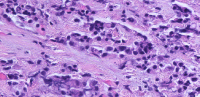

Gabre (CURE) Lab
Principal Investigator
The Columbia UniveRsity Esophageal (CURE) Tissue Culture Lab

Mission
To study and cure rare diseases of the esophagus including esophageal cancer, and esophageal developmental disorders, and esophageal motility disorders
Vision
To be an interdisciplinary lab that integrates clinical outcomes data, multi-omics, and novel 3D culture model systems to develop translational tools to study and treat disorders of the upper GI tract
Approach
To leverage cross-disciplinary skills and peoples from all backgrounds to make meaningful discoveries.
About Dr. Joel Gabre
Dr. Joel T. Gabre is a gastroenterologist and GI cancer genetics specialists interested in studying diseases of the upper GI tract with particular focus on the esophagus. He completed his undergraduate degree at Johns Hopkins University in biophysics, medical degree at the University of Maryland, internal medicine residency at the University of Cincinnati, and gastroenterology fellowship and post-doctoral research fellowship at the University of Pennsylvania, where he was chief GI fellow. He currently serves as Assistant Professor of Medicine at Columbia University Irving Medical Center in the Division of Digestive and Liver Diseases and as a member of the Herbert Irving Comprehensive Cancer Center.
Lab Projects
3D Patient Derived Organoids as a tool To Understand Mechanisms of Chemotherapy and Radiation Resistance in Esophageal Cancer

This project integrates 3D Patient Derived Organoids, Clinical data, and Machine learning to understand how and why some tumors respond to chemotherapy and radiation and others do not.
The Role of EPHA2 in Esophageal Development

This project seeks to understand Tracheo-esophageal separation during early esophageal development with interest in understanding how a receptor tyrosine kinase called EPHA2 mediates this important step.
The Role of the Metaplastic Microenvironment in Promoting the Progression from Intestinal Metaplasia to Cancer in the Esophagus and Stomach
The main goal of our proposed studies is to resolve fundamental gaps in the field of intestinal metaplasia (IM) research using patient derived and induced pluripotent derived (iPSC) organoids. The specific aims of the study include (1) how does gastric IM arise, (2) is there a common molecular pathway initiating IM in the gastric cardia and antrum, and (3) how do TP53 tumor suppressor gene mutations and inflammatory cues each contribute to the initiation of IM.
Our Values
Opportunities for all
We have a philosophy that peoples from all scientific domains and racial/ethnic backgrounds will provide the skills and environment for rapid discovery.
Collaboration
We actively seek collaborations with traditional academic research labs, patient advocacy groups, and industry to advance research in upper GI diseases.
Funding Sources
